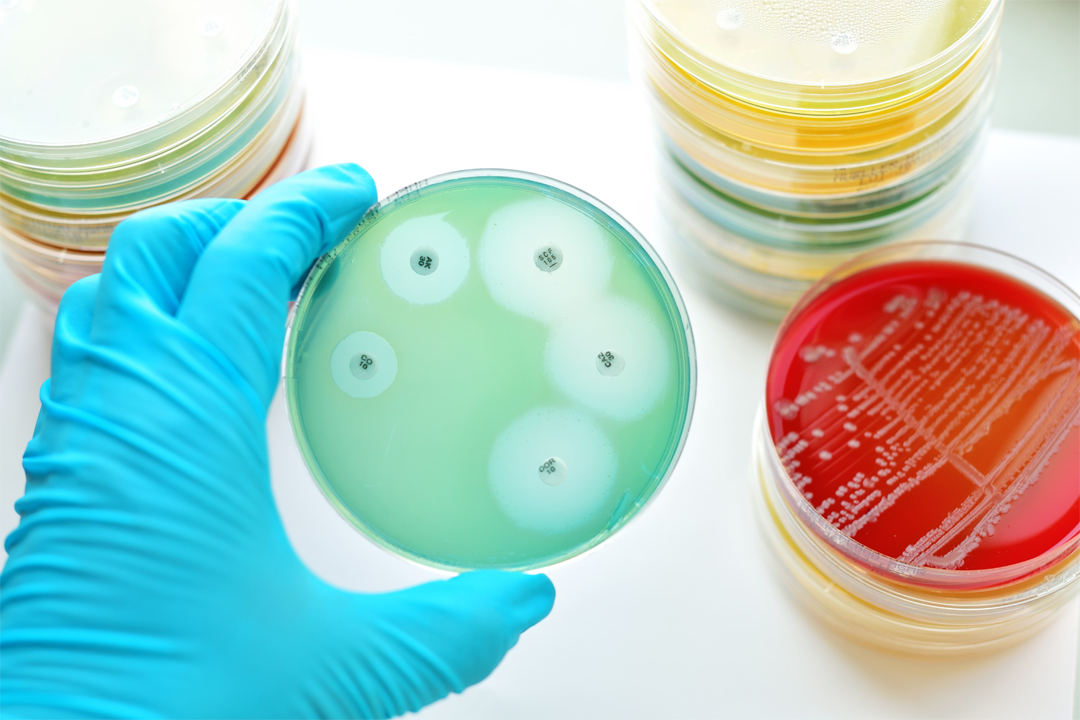

提供氯霉素 chloramphenicol(CAS:56-75-7)等原料,西寶生物值得信賴。
客服熱線:400-021-8158。氯霉素由委內(nèi)瑞拉鏈絲菌產(chǎn)生,對鏈球菌及肺炎球菌、衣原體等均敏感,用于應(yīng)對大腸桿菌、流感桿菌、肺炎球菌等引起的感染。
產(chǎn)品名稱: | 氯霉素 |
英文名稱: | Chloramphenicol |
別名: | chloromycetin |
化學(xué)名稱: | D(-)-蘇-1-對硝基苯基-2-二氯乙酰胺基-1,3-丙二醇 |
CAS: | 56-75-7 |
EINECS號: | 200-287-4 |
結(jié)構(gòu)式: |
|
氯霉素簡介:
氯霉素由委內(nèi)瑞拉鏈絲菌產(chǎn)生、分離得到。對氯霉素敏感的菌比較多,包括:炭疽桿菌及腸桿菌科細(xì)菌、李斯特氏菌、肺炎球菌等,同時也對鉤端螺旋體、立克次體和衣原體有作用,但是氯霉素對造血系統(tǒng)有嚴(yán)重的毒副作用。
氯霉素主要用途:
氯霉素,主要用于應(yīng)對由肺炎球菌、大腸桿菌、流感桿菌、傷寒桿菌等引起的感染,可作為敏感菌引起的感染性診療。氯霉素是用于應(yīng)對傷寒,副傷寒,特別是診療厭氧菌感染。
氯霉素技術(shù)指標(biāo):
純度 | ≥99.0% |
pH 值(10g/l,H2O,20℃) | 5.0~7.0 |
熔點(diǎn) | 149~151℃ |
旋光率 | +17.0~+20.0° |
色譜純度 | PASS |
結(jié)晶度 | PASS |
外觀 | 白色結(jié)晶 |
提供氯霉素 chloramphenicol(CAS:56-75-7)等原料,西寶生物值得信賴。
客服熱線:400-021-8158。氯霉素由委內(nèi)瑞拉鏈絲菌產(chǎn)生的,對鏈球菌及肺炎球菌、衣原體等均敏感,用于應(yīng)對大腸桿菌、流感桿菌、肺炎球菌等引起的感染。
產(chǎn)品名稱: | 氯霉素 |
英文名稱: | Chloramphenicol |
別名: | chloromycetin |
化學(xué)名稱: | D(-)-蘇-1-對硝基苯基-2-二氯乙酰胺基-1,3-丙二醇 |
CAS: | 56-75-7 |
EINECS號: | 200-287-4 |
結(jié)構(gòu)式: |
|
氯霉素簡介:
氯霉素是委內(nèi)瑞拉鏈絲菌產(chǎn)生、分離得到。對氯霉素敏感的菌比較多,包括:炭疽桿菌及腸桿菌科細(xì)菌、李斯特氏菌、肺炎球菌等,同時也對鉤端螺旋體、立克次體和衣原體有作用,但是氯霉素對造血系統(tǒng)有嚴(yán)重的毒副作用。
氯霉素主要用途:
氯霉素,主要用于應(yīng)對由肺炎球菌、大腸桿菌、流感桿菌、傷寒桿菌等引起的感染,可作為敏感菌引起的感染性診療。氯霉素是用于應(yīng)對傷寒,副傷寒,特別是應(yīng)對厭氧菌感染。
氯霉素技術(shù)指標(biāo):
純度 | ≥99.0% |
pH 值(10g/l,H2O,20℃) | 5.0~7.0 |
熔點(diǎn) | 149~151℃ |
旋光率 | +17.0~+20.0° |
色譜純度 | PASS |
結(jié)晶度 | PASS |
外觀 | 白色結(jié)晶 |




